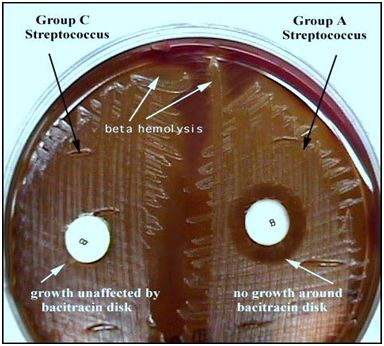

溶血性链球菌的检验
发布时间:2019-09-02 浏览次数:19074
链球菌在自然界中分布较广,存在于水、空气、尘埃、粪便及健康人和动物的口腔、鼻腔、咽喉中,可通过直接接触、空气飞沫传播或通过皮肤、粘膜伤口感染,也可通过被污染的食品如奶、肉、蛋及其制品对人类进行感染。

根据链球菌在血液培养基上生长繁殖后是否溶血及其溶血性质分为三类。
(1)α-溶血性链球菌(α-hemolytic streptococcus):菌落周围有1-2mm宽的草绿色溶血环,环内红细胞未溶解,血红蛋白变成绿色这类链球菌亦称为草绿色链球菌,也称甲型溶血。此类细菌致病力不强,多为条件致病菌。
(2)β-溶血性链球菌(β-hemolytic streptococcus):菌落周围形成一个2-4mm宽、界限分明、完全透明的无色溶血环,也称乙型溶血,因而这类菌亦称为溶血性链球菌,该菌的致病力强,常引起人类和动物的多种疾病。
(3)γ-溶血链球菌(γ-streptococcus):不产生溶血素,菌落周围无溶血环,也称为丙型或不溶血性链球菌(Streptococcus non-hemolytics),该菌无致病性,常存在于乳类和粪便中,偶尔也引起感染。

α、β、γ溶血现象图
在食品标准4789、公共场所标准18204以及卫生标准WS394都有对致病能力强的β-溶血性链球菌的相关检验说明。

标准4789.11-2014的检验流程图
溶血性链球菌在哥伦比亚CNA血琼脂平板上的典型菌落形态为直径约2mm~3mm,灰白色、半透明、光滑、表面突起、圆形、边缘整齐,并产生β 型溶血。

乙型溶血性链球菌
鉴定溶血性链球菌一般要挑取平板上的典型菌落,首先接种哥伦比亚血琼脂平板和TSB增菌液进行分纯培养,然后做革兰氏染色以及触酶实验。
检测步骤一:革兰氏染色镜检
挑取可疑菌落染色镜检。β型溶血性链球菌为革兰氏染色阳性,球形或卵圆形,常排列成短链状。(老龄培养或被中性粒细胞吞噬后,会转为革兰氏阴性。)

链球菌革兰氏染色显微镜图
检测步骤二:触酶试验
挑取可疑菌落于洁净的载玻片上,滴加适量3%过氧化氢溶液,立即产生气泡者为阳性。β型溶血性链球菌触酶为阴性。(链球菌与葡萄球菌不同,不产生过氧化氢酶)

左边为过氧化氢阴性 右边为过氧化氢阳性
检测步骤三:链激酶试验(选做项目)
这个实验所用的血必须是人血,用兔血或者羊血都是做不出来的。
健康人的血浆中含有一种酶原,称为胞浆原。胞浆原在正常状态下不活动,如被溶血性链球菌产生的激活酶作用后,胞浆原即变为活动性的胞浆素,能溶解纤维蛋白,能产生激活酶的链球菌主要有A,C,G等群。凝固块重新完全溶解为阳性,不溶解为阴性,β型溶血性链球菌为阳性。
杆菌肽(bacitracin)敏感试验(4789.11-2003旧标准)
主要用于β型溶血性链球菌的A群与非A群链球菌的鉴别。此法可作为筛选试验。
操作步骤:0.04U杆菌肽药敏纸片贴在涂布有待测菌的血琼脂平板上,36℃培养18-24h后,观察抑菌环以判断是否为敏感。如有抑菌圈出现即为阳性,用已知的阳性菌株(ATCC32210)做对照。
左边是链球菌C群无抑菌圈,
右边是致病性溶血性链球菌A群有抑菌圈






